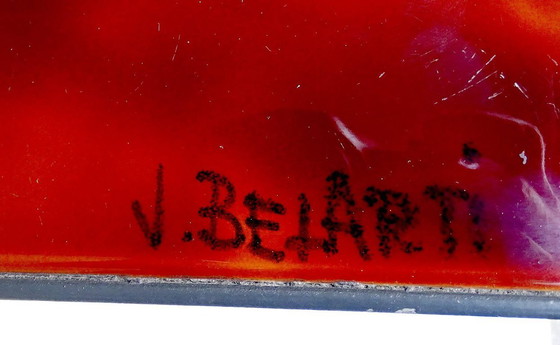
Image 1 of Belarti Mid Century Keramiktisch

Sorgenfreie LieferungKäuferschutzAlle Designerartikel kuratiert von WhoppahLade die Whoppah-App herunter. Immer auf dem Laufenden.

Belarti Mid Century Keramiktisch
1.200 €Bieten ab 980 €
Einkaufen bei Whoppah
Sicher einkaufen & bezahlen mit KäuferschutzAlle Designerartikel sind 100% authentischWir zahlen den Verkäufer erst aus, wenn du den Artikel einwandfrei erhalten hastSichere Zahlungsmethoden
Über diesen Verkäufer
ProfessionellDötlingen, DeutschlandBei Whoppah seit Februar 2023 • 54 Verkäufe
Beschreibung des Produkts
Großer Mid-Century-Tisch mit handgefertigten Keramikfliesen und Chromgestell. Die original spanischen glasierten Fliesen auf der Tischplatte wurden in geflammten Farbtönen von dunklem Kastanienbraun über Sienagelb/Orange bis hin zu Bordeaux gefertigt. Die Fliesen sind in ein anthrazitfarbenes, emailliertes Stahlgehäuse eingebettet. Der verchromte Metallfuß und die Leisten verleihen dem Tisch seine luftige Note und modernistische, zeitlose Eleganz.
einige feine Kratzer durch die Nutzung, hauptsächlich an der Unterseite der Beine, ein schwacher Fleckenkranz auf einer Fliese
einige feine Kratzer durch die Nutzung, hauptsächlich an der Unterseite der Beine, ein schwacher Fleckenkranz auf einer Fliese
Spezifikationen
ZustandSehr gutFarbenBraun, Rot, Mehrfarbig, SilberMaterialKeramik, Metall, ChromAnzahl der Artikel1MarkeBelartiHöhe51 cmBreite166 cmTiefe66 cm
Entdecken Sie mehr
Verkäuferinformationen
Über diesen Verkäufer
ProfessionellDötlingen, DeutschlandBei Whoppah seit Februar 2023 • 54 Verkäufe